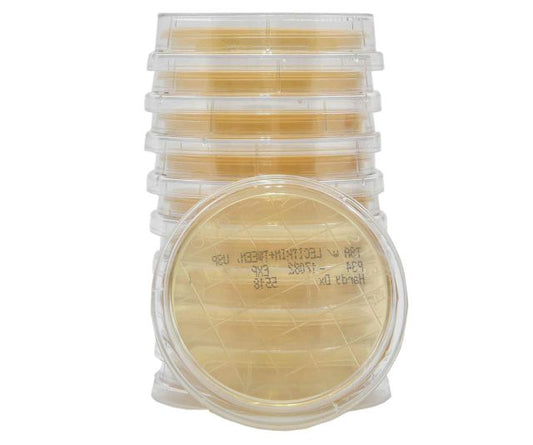
Hardy Diagnostics P34 – TSA with Lecithin & Tween Contact Plates | Surface & Gloved Fingertip Testing for Compounding Pharmacies, USP, 15x65mm Contact Plate, 10 per package

-
Hardy Diagnostics P34 – TSA with Lecithin & Tween Contact Plates | Surface & Gloved Fingertip Testing for Compounding Pharmacies, USP, 15x65mm Contact Plate, 10 per package
Regular price $28.93 USDRegular priceUnit price / per